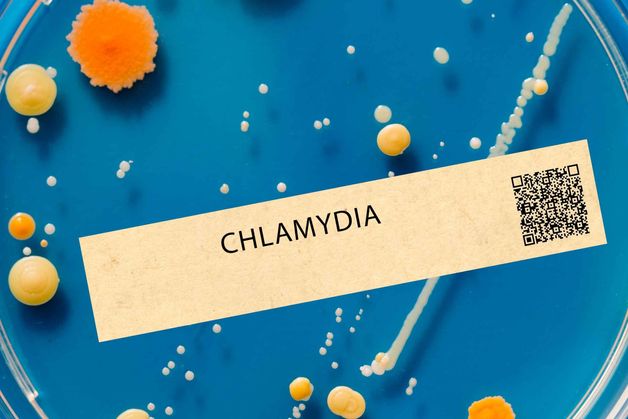
Chlamydie: nejčastější skrytá infekce. Jak ji diagnostikujeme?

Venerologie
Venerologie: Diskrétní vyšetření a odborná péče o intimní zdraví
Zdraví v intimní oblasti je citlivým, ale velmi důležitým tématem. Pohlavně přenosné nemoci (STD) postihují ženy i muže bez ohledu na věk či životní styl, a jejich včasné rozpoznání a léčba jsou klíčem k ochraně vašeho zdraví i zdraví partnera. Na klinice Vasmedic poskytujeme diskrétní a odbornou péči v oblasti venerologie – oboru zaměřeného na diagnostiku, léčbu a prevenci pohlavních chorob.